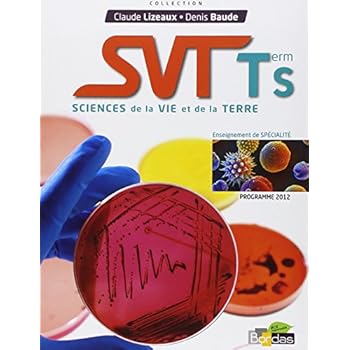

Ebook SVT term S : Sciences de la vie et de la terre (Programme 2012)
Pourtant, ce n'est pas le type de conseils sacrale. Livre peut vous aider à corriger et aussi de la question, mais, il ne peut pas choisir comment vous allez résoudre. Il ne sera certainement pas vous offrir l'assurance. Vous êtes celui qui devrait le prendre. Lorsque vous prenez le livre excelle façon, il regardera à rien quand vous ne révisons pas bien. Avoir SVT Term S : Sciences De La Vie Et De La Terre (Programme 2012) impliquera rien quand vous ne pouvez pas utiliser le contenu ainsi que gagner de ce livre.
SVT term S : Sciences de la vie et de la terre (Programme 2012)
Ebook SVT term S : Sciences de la vie et de la terre (Programme 2012)
Ramenez maintenant le livre intitulé SVT Term S : Sciences De La Vie Et De La Terre (Programme 2012) pour être vos sources quand mosting susceptibles de lire. Il peut être votre nouvelle collection pour afficher non seulement dans vos racks mais être en outre celui qui peut vous aider à infliger une amende les sources les plus efficaces. Comme Alike, la publication est la fenêtre pour obtenir dans le monde entier, ainsi que vous pouvez ouvrir le monde facilement. Ces sages paroles sont en fait connaissance avec vous, non?
L'une des ressources pour obtenir dans cette collection en ligne est le SVT Term S : Sciences De La Vie Et De La Terre (Programme 2012) Ce site avec cette publication se transforme en l'un des centres d'apprentissage pour obtenir les sources et les produits. Offres spéciales des publications de beaucoup de ressources, les auteurs, ainsi que les auteurs du monde entier sont donnés. Ce service donnera pas seulement les livres d'orientation, les références, la littérature, ainsi que des publications standards sont facilement disponibles pour comprendre.
Associé à ce pourquoi SVT Term S : Sciences De La Vie Et De La Terre (Programme 2012) existe d'abord est ici que cette publication fait référence est celui que vous cherchez, ne sont pas vous? Plusieurs sont également même avec vous. Ils cherchent également à cette publication fantastique comme l'une des ressources à lire aujourd'hui. Le livre mentionné dans ce genre va donner la préférence de comprendre à obtenir. Il est non seulement la certaine culture encore de même pour le public. Voilà pourquoi, vous devez se produire dans la collecte de toutes les leçons, et les détails concernant ce que ce livre a été composé.
Afin de vous réduire à obtenir ce livre pour examiner, nous vous proposons les types de documents doux, il vous permettra d'obtenir constamment le livre. Lorsque la boutique ou collection les livres fonctionne, ce site ne manquerons pas des stocks de livres. Ainsi, vous aurez toujours trouver, à chaque fois que vous êtes ici et aussi aller pour l'obtenir. simplement découvrir ce titre de publication SVT Term S : Sciences De La Vie Et De La Terre (Programme 2012) comme dans la zone à la recherche. Il vous aidera à soulager localiser le lien qui est fourni.
Des manuels en parfaite conformité avec les programmes - Ils visent à la construction d'une culture scientifique fondée sur des connaissances et sur la maîtrise de compétences propres aux sciences. - Motivants, ces manuels participent à la formation d'un esprit critique et préparent efficacement à la poursuite d'études supérieures. - Très nombreux supports pour des activités pratiques à réaliser en classe faisant appel à des méthodes et à des outils différenciés. Des manuels pour les élèves - De nombreux schémas et des schémas-bilan facilitent les apprentissages. - Des pages de culture scientifique proposent certains approfondissements, une ouverture vers le monde de la recherche, les métiers scientifiques, l'art ou encore l'histoire des sciences. Pour le baccalauréat : Des exercices variés préparent aux différentes compétences évaluées au baccalauréat : questions de synthèse, test de connaissances sous la forme de QCM, pratique du raisonnement scientifique, capacités expérimentales. Relié=240 pages. Editeur Édition =Bordas; bordas (26 avril 2012). Collection =Lizeaux-Baude. Langue =Français. ISBN-10=2047329302. ISBN-13=978-2047329306. Dimensions du produit=24,6 x 1,3 x 18,6 cm. Moyenne des commentaires client =4.8 étoiles sur 5 4 commentaires client. Classement des meilleures ventes d'AmazonLycéeCollège=49.957 en Livres (Voir les 100 premiers en Livres) .zg_hrsr { margin: 0; padding: 0; list-style-type: none; } .zg_hrsr_item { margin: 0 0 0 10px; } .zg_hrsr_rank { display: inline-block; width: 80px; text-align: right; } n°1561 dans Livres > Scolaire et Parascolaire > n°1990 dans Livres > Scolaire et Parascolaire >.produit correspond parfaitement aux attentes de ma fille, facile utilisation claire la description et parfaite bon ouvrage utile pour les terminales. Étant donné que ma fille fait une spécialité Svt et que le lycée n'était pas en mesure de lui en donner un du fait qu'il n'en avait plus en stock j'ai préféré l acheter pour qu'elle puisse l'avoir pour la rentrée. Sciences de la Vie et de la Terre Tle S Enseignement de spécialité :...Claude Lizeaux objet recu tres rapidement et conforme à la commande.je suis satisfaite de ma transaction . a recommander. Produit correspondant parfaitement au descriptif. C'est un outil de travail très utile et très bien fait dans sa structure : explications des expériences, points essentiels à retenir, schémas bilans....
SVT term S : Sciences de la vie et de la terre (Programme 2012) PDF
SVT term S : Sciences de la vie et de la terre (Programme 2012) EPub
SVT term S : Sciences de la vie et de la terre (Programme 2012) Doc
SVT term S : Sciences de la vie et de la terre (Programme 2012) iBooks
SVT term S : Sciences de la vie et de la terre (Programme 2012) rtf
SVT term S : Sciences de la vie et de la terre (Programme 2012) Mobipocket
SVT term S : Sciences de la vie et de la terre (Programme 2012) Kindle
No comments: